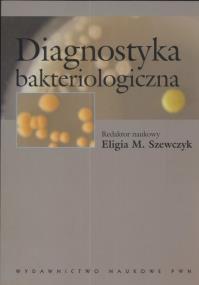
Opakowanie Diagnostyka bakteriologiczna

Kategorie
|
|
Diagnostyka bakteriologicznaNie ma jeszcze oceny, możesz być pierwszym, który ocenił!
Wydawca:
ISBN:
9788301144739
EAN:
978830114473904
Oprawa:
Miękka
Język:
polski
Format:
17.0x24.0cm
Liczba stron:
362
Rok wydania:
2005
wysyłka:
niedostępny
40,57
zł
Cena detaliczna:
49,90 zł
Produkt niedostępny
Najniższa cena z ostatnich 30 dni: 40,57 zł
W książce przedstawiono problemy diagnostyki bakteriologicznej uwzględniając 2 aspekty:
* szeroki przegląd bakterii związanych z człowiekiem
podstawy taksonomii bakterii, aktualna systematyka, dane dotyczące źródeł i rezerwuarów bakterii, najważniejsze cechy patogenezy i przebiegu zakażeń, rodzaje materiału klinicznego w diagnostyce chorób, szczegółowa charakterystyka tych cech ekologii, morfologii i metabolizmu bakterii, które mogą być wykorzystane w diagnostyce, a także tradycyjne i najnowsze metody identyfikacyjne (biologia molekularna);
* postępowanie diagnostyczne
przegląd materiałów klinicznych, sposoby ich pobierania, przechowywania i transportu, najkorzystniejsze metody identyfikacyjne i diagnostyczne, praktyczne schematy postępowania w badaniu materiałów klinicznych.
Książka przeznaczona dla studentów mikrobiologii, biotechnologii i ochrony środowiska, medycyny, pracowników laboratoriów mikrobiologicznych, stacji sanitarno-epidemiologicznych oraz lekarzy, zwłaszcza specjalizujących się w mikrobiologii.
Brak recenzjix
Uwaga!!!
Ten produkt jest zapowiedzią. Realizacja Twojego zamówienia ulegnie przez to wydłużeniu do czasu premiery tej pozycji. Czy chcesz dodać ten produkt do koszyka?
TAK
NIE


Wybierz wariant produktu
|
|